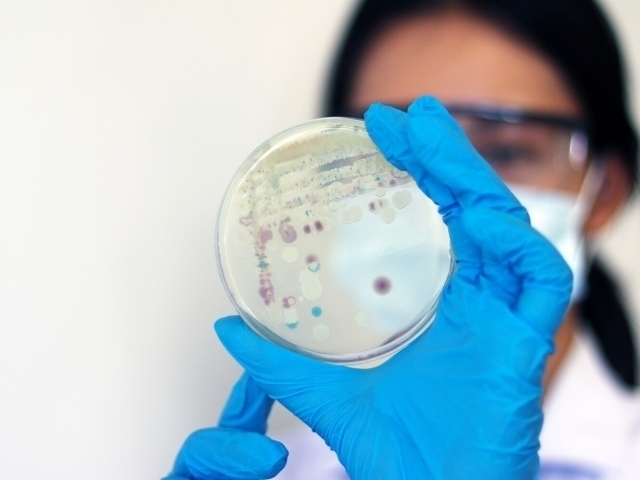
image

Olimlar Yerdagi eng qadimiy zamburug‘ni aniqladi
Olam
−
13 noyabr 2025 2186 2 daqiqa
Kembrij universitetining Seynsberi laboratoriyasi (SLCU) olimlari Shotlandiyada joylashgan Uinfild slanetslarida (tosh) 407 million yil avvalgi qadimiy zamburug‘ qoldig‘ini topdi. Bu haqdagi tadqiqot “New Phytologist” jurnalida e’lon qilindi.
Qayd etilishicha, topilma o‘simliklar va zamburug‘lar o‘rtasidagi ilk “hamkorlik” – mikorizaning mavjudligini tasdiqlagan. Mikoriza o‘zaro foydali ittifoq bo‘lib, unda zamburug‘lar o‘simliklarga suv va ozuqa moddalarning singishini osonlashtirib, o‘simliklar esa ularga shakar moddalarini yetkazib beradi. Bunday hamkorlik bugungi ko‘plab ekotizimlarning asosini tashkil etadi va o‘simliklar oziqlanishida muhim rol kasb etadi.
Yangi aniqlangan zamburug‘ turi Rugososporomyces lavoisierae deb nomlangan. U qadimgi Aglaophyton majus o‘simligi bilan simbiotik aloqada bo‘lgan va shu tur bilan bog‘liq ikkinchi zamburug‘ sifatida qayd etilgan.
Olimlar namunani o‘rganishda zamonaviy mikroskopiya usullaridan foydalangan. Bu usullar orqali o‘simlik va zamburug‘ hujayralarini bir-biridan farqlagan. Shuningdek, ular qadimiy to‘qimalarning yorug‘lik signaturalari ya’ni optik izlarni tahlil qilib, hatto DNK yo‘qolganiga qaramay, zamburug‘ mavjudligini isbotlagan.
“Zamburug‘ning tarmoqlangan ipchalari arbuskulalar mavjudligi uning parazit emas, balki o‘simlik bilan o‘zaro foydali ittifoqda yashaganini ko‘rsatadi. U fosfor kabi minerallarni o‘simlikdan olgan shakar evaziga almashgan. Bu kashfiyot o‘simliklar va zamburug‘lar qanday qilib birgalikda quruqlikka moslashib, bugungi hayot asosini tashkil etgan ekotizimlarni yaratganini tushunishga yordam beradi,” deydi tadqiqot rahbari, doktor Kristin Strullu-Derriyen.
Eslatib o‘tamiz avvalroq, AQSHning Texas shtatidagi ikkita shifoxonada dori-darmonlarga chidamli Candida auris zamburug‘i kasalligi tarqalgandi va u to‘rt nafar bemorning o‘limiga sabab bo‘lgan edi.
Mohichehra Qadamova
Live
Barchasi